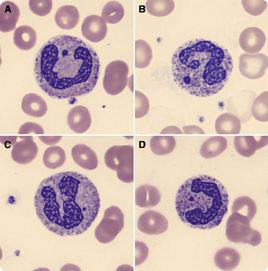
微核

含義
微核微核(micronucleus, 簡稱MCN),也叫衛星核,是真核類生物細胞中的一種異常結構,是染色體畸變在間期細胞中的一種表現形式。微核往往是各種理化因子,如輻射、化學藥劑對分裂細胞作用而產生的。
傳統用途
在細胞間期,微核呈圓形或橢圓形,游離於主核之外,大小應在主核1/3以下。微核的折光率及細胞化學反應性質和主核一樣,也具合成DNA的能力。一般認為微核是由有絲分裂後期喪失著絲粒的染色體斷片產生的。有實驗證明,整條染色體或幾條染色體也能形成微核。這些斷片或染色體在分裂過程中行動滯後,在分裂末期不能進入主核,便形成了主核之外的核塊。當子細胞進入下一次分裂間期時,它們便濃縮成主核之外的小核,即形成了微核。已經證實,微核率的大小是和作用因子的劑量或輻射累積效應呈正相關,這一點與染色體畸變的情況一樣。所以許多人認為可用簡易的周期微核計數來代替繁雜的中期畸變染色體計數。由於大量新的化合物的合成,原子能的套用,各種各樣工業廢物的排出等都存在污染環境的可能性,欲了解這些因素對機體潛在的遺傳危害,需要有一套高度靈敏,技術簡單易行的測試系統來監測環境的變化。只有真核類的測試系統更能直接推測誘變物質對人類或其它高等生物的遺傳危害,在這方面,微核測試是一種比較理想的方法。目前國內外不少部門已把微核測試用於輻射損傷、輻射防護、化學誘變劑、新藥試驗、食品添加劑的安全評價,以及染色體遺傳疾病和癌症前期診斷等各個方面。
近年來,國內學者用蠶豆根尖微核技術檢測具有誘變活性的污水、化學藥品、農藥等.但均為誘變劑單獨作用時的誘變效應.本試驗利用蠶豆根尖微核技術,研究農業生產中常用農藥甲胺磷、甲基硫菌靈、鹽酸嗎啉胍在規定使用濃度範圍內,單獨和聯合作用時對蠶豆根尖細胞的遺傳毒性,以探討其毒理作用及是否存在拮抗或協同效應,為農業生產上安全合理使用農藥和污染治理提供科學依據.
新興用途
70年代初,Matter和Schmid首先用嚙齒類動物骨髓細胞微核率來測定疑有誘變活力的化合物,建立了微核測定法。此後,微核測定逐漸從動物、人擴展到植物領域。人和動物的微核測試多用骨髓和外周血細胞,這需要一定的培養條件與時間,細胞同步化困難,微核率低,一般只在0.2%左右。而植物系統則更直接、更簡便。如採用高等植物花粉孢子利用其天然的同步性作微核測試材料,取得較好效果,其中70年代末Te-Hsiu Ma用一種原產於美洲的鴨跖草(Tradescantia paludosa),建立的四分孢子期微核率計數(MCN-in-tetrad)的測試系統是較好的系統之一。華中師範大學生物系自1983年開始,建立了一套蠶豆根尖微核測試,並首次用於監測水環境污染,經鑑定已列入國家《生物監測技術規範(水環境部分)》。微核是細胞的染色體發生斷裂後,細胞進入下一次分裂時,染色體片段不能隨有絲分裂進入子細胞,而在細胞漿中形成直徑小於主核的,嗜色與主核一致,完全與主核分開的圓形或橢圓形微小核 ,位於細胞漿中獨立於主核的核小體,其染色同主核,但比主核淡,其直徑小於主核1/3,主要由外界損害因素(生物、物理、化學)作用細胞後,導致細胞染色體丟失或斷裂,從而在胞漿中形成1個或數個微核。
微核實驗
微核試驗在對外來化合物(如藥品、食品添加劑、農藥、化妝品、環境污染物等)遺傳毒性和職業暴露人群遺傳損害監測和現場生態環境檢測方面,在診斷和預防肝癌、食管癌、肺癌等惡性腫瘤方面得到了大量的套用。微核試驗最大的優點是經濟、簡單、快速,而國內外大量的對試驗研究,比較一致的看法是該方法在敏感性、特異性和準確性方面,與經典的染色體畸變分析方法基本相當川。因而,特別適合作為大量化合物和現場人群初篩的實驗方法。微核試驗創建於20世紀70年代中期(1973~1975)[3.‘〕,目前許多國家和國際組織,已將其規定為新藥、食品添加劑、農藥、化妝品等毒理安全性評價的必做實驗〔5一8〕。
新微核實驗
近年來,隨著分子生物學技術的迅速發展和滲透到微核研究中,大大拓展了微核試驗的檢測和套用範圍,已發展成為能同時檢測染色體斷裂、丟失、分裂延遲、分裂不平衡、基因擴增、不分離、DNA損傷修復障礙、HPrt基因突變、凋亡、細胞分裂不平衡等多種遺傳學終點的檢測,因而近年來國際上有人提出了新微核試驗(newmi一cronucleustest)概念,從而大大拓展了微核試驗的套用範圍。當然,要實現一個實驗多個遺傳損害終點的檢測,需要更多的新的技術手段配合,如FISH技術、圖象分析卜技術等等,這也對我國的實驗室條件和研究水平提出了更高的要求。